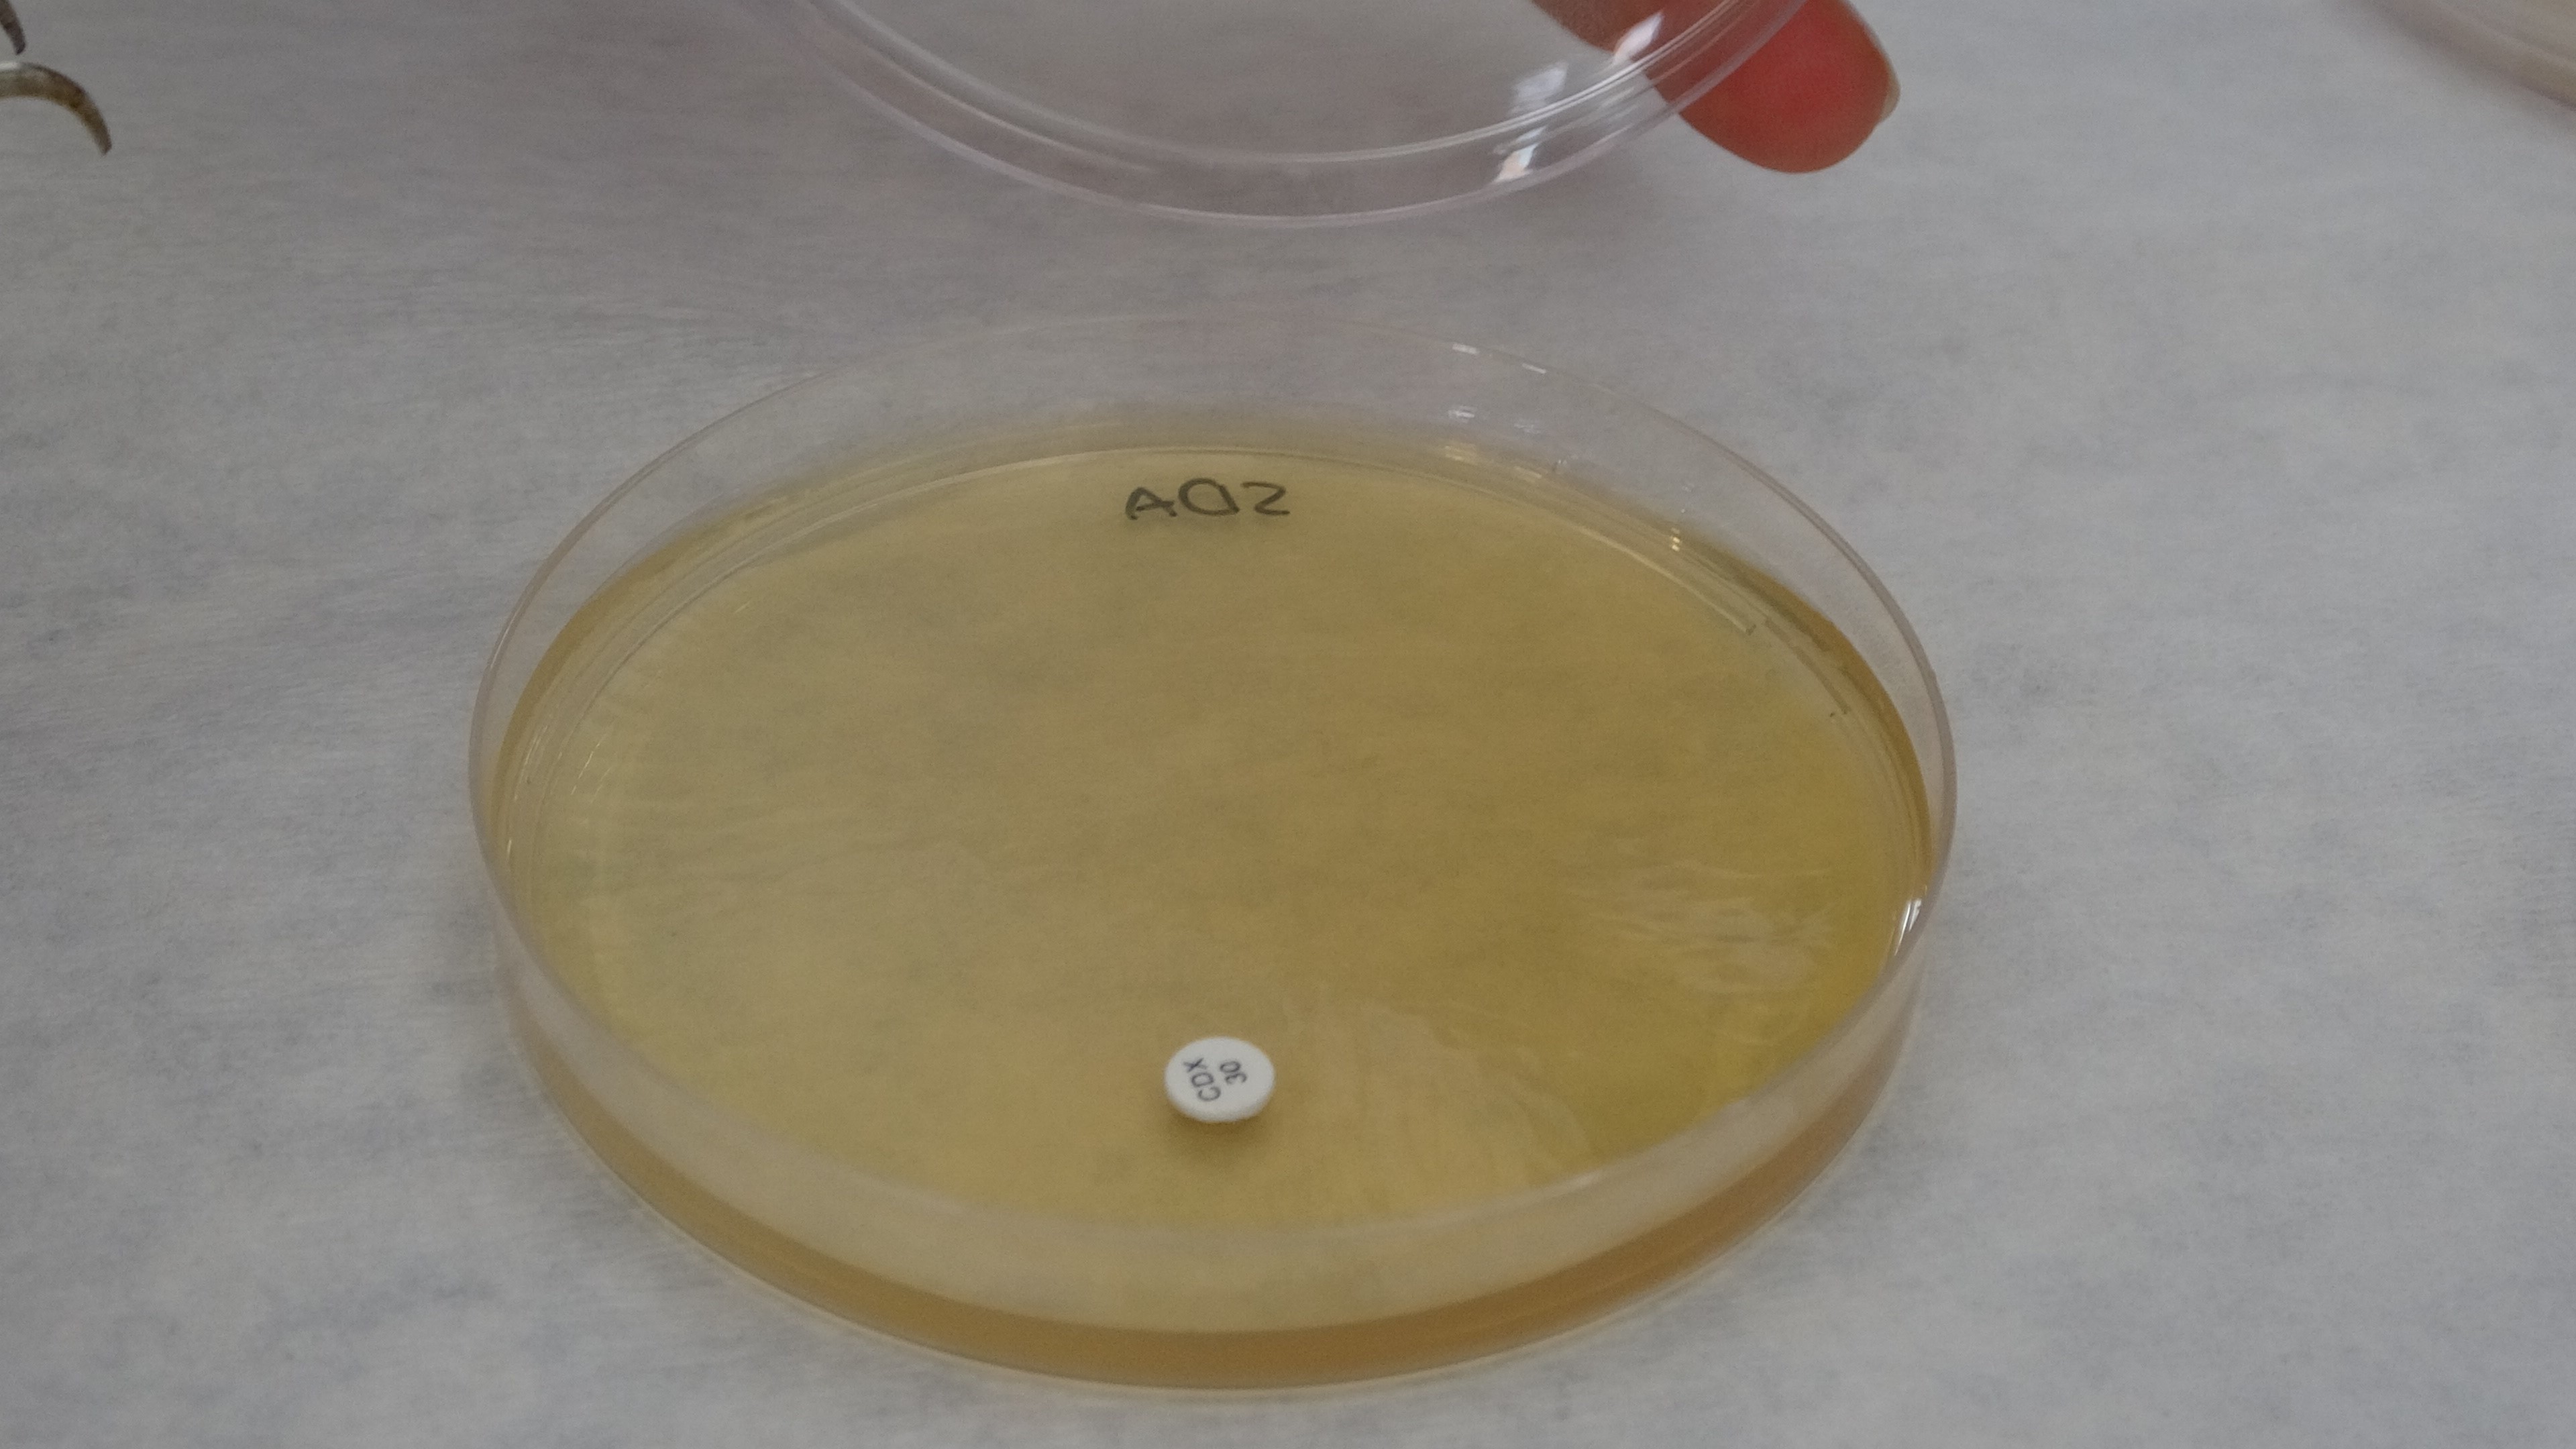
Sarı Kantaron Devri Bitiyor MuU

Malatya florasında yetişen endemik bir bitki olan Hypericum malatyanum (Malatya kantaronu), bilimsel bir araştırmanın konusu oldu. Malatya Turgut Özal Üniversitesi ve İnönü Üniversitesi akademisyenlerinin ortak çalışmasında, Malatya kantaronu ile tıbbi olarak bilinen Hypericum perforatum (sarı kantaron) türlerinin kimyasal bileşimleri detaylıca karşılaştırıldı.

"Malatya Kantaronu Kimyasal Olarak Çok Zengin"
Çalışmayı yürüten Prof. Dr. Şanlı Kabaktepe, araştırmalarının özgünlüğünün iki türün detaylı kimyasal ve element analizleriyle karşılaştırılması olduğunu belirtti. Kabaktepe, yapılan analizler sonucunda Malatya kantaronunun birçok kimyasal özelliğiyle çok değerli ve zengin bir yapıya sahip olduğunu bilimsel olarak kanıtladıklarını açıkladı.
Antioksidan Aktivitesi %90'a Ulaştı
Araştırma ekibinden Dr. Öğr. Üyesi Elif Özbey, Malatya kantaronunun ekolojik şartlara özgü zengin fitokimyasal içeriğinin altını çizdi. Özbey, endemik türün antioksidan aktivitesinin konsantrasyona bağlı olarak yüzde 90'a varan radikal süpürücü etki gösterdiğini tespit ettiklerini belirterek, bu durumun bitkinin oksidatif stresle mücadelede önemli bir doğal kaynak olduğunu gösterdiğini söyledi.

Mikroorganizmalara Karşı Güçlü Potansiyel
Araştırmada ayrıca, iki kantaron türünün farklı mikroorganizmalara karşı gösterdiği antimikrobiyal etkiler de incelendi. Dr. Öğr. Üyesi Elif Özbey, her iki türün farklı kimyasal profillere sahip olması nedeniyle, terapötik potansiyellerinin de birbirinden farklı olduğunu ve mikrobiyal savaşta güçlü bir etkiye sahip olduğunu kaydetti.

İlaç ve Kozmetikte Kullanım Alanı
Çalışmanın sonuçları, Malatya kantaronunun gelecekteki kullanım alanlarına ışık tutuyor. Zengin kimyasal yapısı sayesinde bitkinin, ilaç sanayisi, gıda ve kozmetik sektörlerinde potansiyel kullanım alanlarının bulunduğunu ifade eden Özbey, bu endemik bitkinin bilimsel yönlerinin ortaya çıkarılmasının ve korunmasının önemine dikkat çekti.




